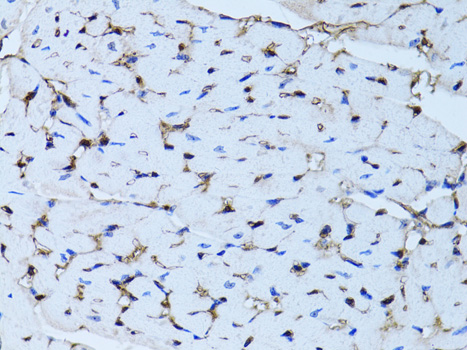

Product Detail
Product NameFABP4 Antibody
Host SpeciesRabbit
ClonalityPolyclonal
PurificationAntibodies were purified by affinity purification using immunogen.
ApplicationsWB,IHC,IF
Species ReactivityHuman,Mouse,Rat
SpecificityThe antibody detects endogenous level of total FABP4 protein.
Immunogen TypeRecombinant Protein
Immunogen DescRecombinant protein of human FABP4.
Target NameFABP4
ConjugateUnconjugated
Other NamesFABP4; aP2; ALBP; Fattyacidbindingprotein4; AFABP
Accession NoSwiss-Prot:P15090
NCBI Gene ID:2167
Uniprot
P15090
Gene ID
2167;
Sdspage MW15KD
Concentration1.0mg/ml
FormulationSupplied at 1.0mg/mL in phosphate buffered saline (without Mg2+ and Ca2+), pH 7.4, 150mM NaCl, 0.02% sodium azide and 50% glycerol.
StorageStore at -20˚C
Application Details
WB 1:500 - 1:2000
IHC 1:50 - 1:200
IF 1:50 - 1:200
Western blot analysis of extracts of various cell lines, using FABP4 .
Immunohistochemistry of paraffin-embedded rat heart using FABP4 at dilution of 1:100 (40x lens).
Immunohistochemistry of paraffin-embedded human breast cancer using FABP4 at dilution of 1:100 (40x lens).
Immunohistochemistry of paraffin-embedded mouse heart using FABP4 at dilution of 1:100 (40x lens).
Immunofluorescence analysis of A549 cells using FABP4 . Blue: DAPI for nuclear staining.
Fatty acid binding proteins (FABPs) bind to fatty acids and other lipids to function as cytoplasmic lipid chaperones (1). They participate in the transport of fatty acids and other lipids to various cellular pathways (2). The predominant fatty acid binding protein found in adipocytes is FABP4, also called adipocyte fatty acid binding protein or aP2. FABP4 is also expressed in macrophages (3). FABP4 knockout mice fed a high-fat and high-calorie diet become obese but develop neither insulin resistance nor diabetes, suggesting that this protein might be a link between obesity and insulin resistance and diabetes (4). Mice deficient in both FABP4 and ApoE show protection against atherosclerosis when compared with mice deficient only in ApoE (3). Mice carrying a FABP4 genetic variant exhibit both reduced FABP4 expression and a reduced potential for developing type 2 diabetes and coronary heart disease. A related study in humans indicated a similar pattern, suggesting that FABP4 may be a potential therapeutic target in the treatment of these disorders (1).
If you have published an article using product 32030, please notify us so that we can cite your literature.
et al,FABP4 accelerates glioblastoma cell growth and metastasis through Wnt10b signalling.In Eur Rev Med Pharmacol Sci.On 2018 Nov by Li HY, Lv BB et al..PMID:30536325
, (2018),
PMID:
30536325

Yes
Yes



